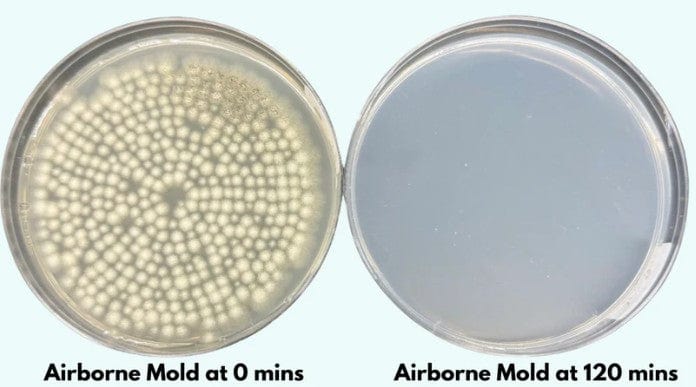
Jaspr Air Purifier

Description
Air quality emerged as a critical factor in my recovery. The Jaspr Air Purifier changed my home into a true healing sanctuary by eliminating airborne toxins that continuously challenged my overburdened detoxification pathways. Unlike basic filters, their sophisticated technology removes pollutants, allergens, VOCs, mold spores, and viruses—all triggers that previously sent me into symptom spirals.
The whisper-quiet operation and elegant design made it practical for bedrooms and living spaces where I spent most recovery time. My breathing improved, sleep deepened, and cognitive function sharpened as my system no longer battled constant inhalation of irritants. The investment in clean air yielded some of the most noticeable improvements in my day-to-day symptoms. (Now, when I travel and have to stay in hotels, I bring it with me!)